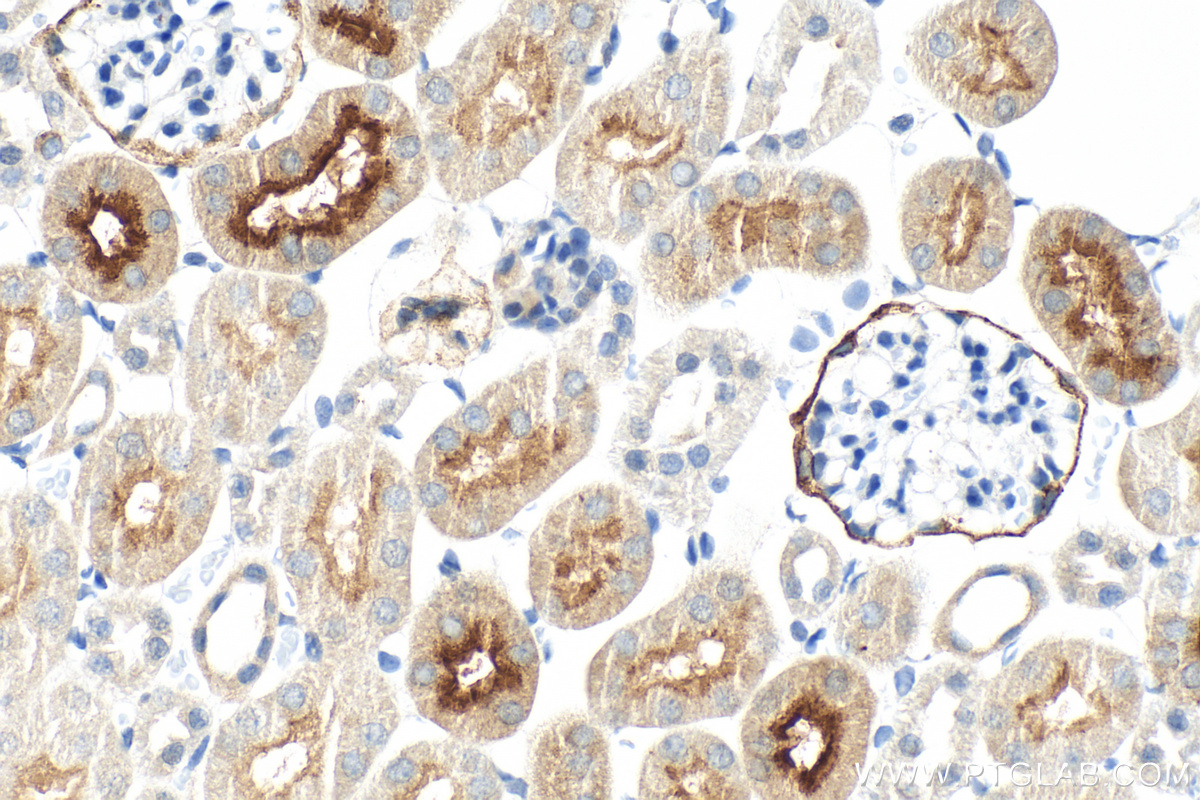

Tested Applications
| Positive WB detected in | LNCaP cells, human liver tissue, mouse kidney tissue, rat kidney tissue |
| Positive IHC detected in | human prostate cancer tissue, human colon cancer tissue, human gliomas tissue, mouse kidney tissue, rat kidney tissue Note: suggested antigen retrieval with TE buffer pH 9.0; (*) Alternatively, antigen retrieval may be performed with citrate buffer pH 6.0 |
| Positive IF/ICC detected in | LNCaP cells |
Recommended dilution
| Application | Dilution |
|---|---|
| Western Blot (WB) | WB : 1:1000-1:4000 |
| Immunohistochemistry (IHC) | IHC : 1:500-1:2000 |
| Immunofluorescence (IF)/ICC | IF/ICC : 1:50-1:500 |
| It is recommended that this reagent should be titrated in each testing system to obtain optimal results. | |
| Sample-dependent, Check data in validation data gallery. | |
Published Applications
| WB | See 6 publications below |
| IHC | See 5 publications below |
| IF | See 1 publications below |
Product Information
13163-1-AP targets PSMA/GCPII in WB, IHC, IF/ICC, ELISA applications and shows reactivity with human, mouse, rat samples.
| Tested Reactivity | human, mouse, rat |
| Cited Reactivity | human, mouse, rat, monkey |
| Host / Isotype | Rabbit / IgG |
| Class | Polyclonal |
| Type | Antibody |
| Immunogen |
CatNo: Ag3812 Product name: Recombinant human FOLH1 protein Source: e coli.-derived, PGEX-4T Tag: GST Domain: 45-385 aa of BC025672 Sequence: SSNEATNITPKHNMKAFLDELKAENIKKFLYNFTQIPHLAGTEQNFQLAKQIQSQWKEFGLDSVELAHYDVLLSYPNKTHPNYISIINEDGNEIFNTSLFEPPPPGYENVSDIVPPFSAFSPQGMPEGDLVYVNYARTEDFFKLERDMKINCSGKIVIARYGKVFRGNKVKNAQLAGAKGVILYSDPADYFAPGVKSYPDGWNLPGGGVQRGNILNLNGAGDPLTPGYPANEYAYRRGIAEAVGLPSIPVHPIGYYDAQKLLEKMGGSAPPDSSWRGSLKVPYNVGPGFTGNFSTQKVKMHIHSTNEVTRIYNVIGTLRGAVEPDRYVILGGHRDSWVFGG Predict reactive species |
| Full Name | folate hydrolase (prostate-specific membrane antigen) 1 |
| Calculated Molecular Weight | 719 aa, 81 kDa |
| Observed Molecular Weight | 100 kDa, 120 kDa |
| GenBank Accession Number | BC025672 |
| Gene Symbol | PSMA |
| Gene ID (NCBI) | 2346 |
| RRID | AB_2106442 |
| Conjugate | Unconjugated |
| Form | Liquid |
| Purification Method | Antigen affinity purification |
| UNIPROT ID | Q04609 |
| Storage Buffer | PBS with 0.02% sodium azide and 50% glycerol, pH 7.3. |
| Storage Conditions | Store at -20°C. Stable for one year after shipment. Aliquoting is unnecessary for -20oC storage. 20ul sizes contain 0.1% BSA. |
Background Information
PSMA(Prostate-specific membrane antigen) is also named as FOLH1, FOLH, NAALAD1, PSM and belongs to the peptidase M28 family. PSMA is a 100-120 kDa integral transmembrane glycoprotein, considered to be a highly specific marker of the prostate gland, and has successfully been used as a marker of circulating prostatic epithelial cells(PMID:10074909; 15680901). It is involved in conversion of the major neurotransmitter (NAAG) to NAA and free glutamate. It has 8 isoforms produced by alternative splicing.
Protocols
| Product Specific Protocols | |
|---|---|
| IF protocol for PSMA/GCPII antibody 13163-1-AP | Download protocol |
| IHC protocol for PSMA/GCPII antibody 13163-1-AP | Download protocol |
| WB protocol for PSMA/GCPII antibody 13163-1-AP | Download protocol |
| Standard Protocols | |
|---|---|
| Click here to view our Standard Protocols |
Publications
| Species | Application | Title |
|---|---|---|
ACS Sens Rolling Circle Amplification-Assisted Flow Cytometry Approach for Simultaneous Profiling of Exosomal Surface Proteins. | ||
J Nucl Med Molecular imaging of Neuroendocrine Prostate Cancer by targeting Delta-like Ligand 3. | ||
J Control Release PSMA-targeted nanoparticles for specific penetration of blood-brain tumor barrier and combined therapy of brain metastases. | ||
Front Pharmacol Increasing Aspartoacylase in the Central Amygdala: The Common Mechanism of Gastroprotective Effects of Monoamine-Based Antidepressants Against Stress. | ||
bioRxiv Dysregulated calcium signaling in the aged macaque entorhinal cortex associated with tau hyperphosphorylation |